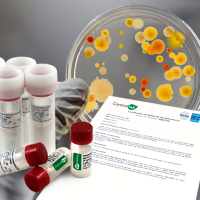
MRC Culturas de Referência Qualitativa ATCC, MRC

Uso de cepas de referência: da escolha à aplicação
Subtítulo do encontro (caso se aplique)
- 06/11 às 15h
(horário de Brasília)
Participe do Encontro Online “Uso de cepas de referência: da escolha à aplicação” da Controllab.
📅 Data: 06/11 (quinta-feira)
⏰ Horário: 15h (Brasília)
Quais temas serão apresentados?
- Importância do uso de cepas de referência
- Impacto do uso inadequado dessas cepas
- Normas e regulamentações que exigem o seu uso
- Critérios para escolha adequada das cepas
- Técnicas corretas de conservação
- Erros mais comuns na rotina laboratorial
- Boas práticas e biossegurança
⚡ As vagas são limitadas! Inscreva-se agora e participe ao vivo para tirar suas dúvidas diretamente com a especialista.

Julia Baruque
Bacharel em Microbiologia e Imunologia (UFRJ), Mestre em Engenharia de Processos Bioquímicos (UFRJ) e Analista Técnica na Controllab.

Dr. José Antônio Tesser Poloni
Farmacêutico-bioquímico graduado pela PUCRS, mestre e doutor em Ciências da Saúde pela UFCSPA, gestor educacional e consultor para Uroanálise na Controllab.
100% Online
Acesse a aula
de onde estiver
Dúvidas
20 minutos para
esclarecimentos
Certificados
Você recebe a certificação
de participação